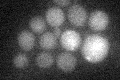
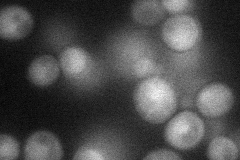
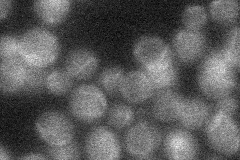

View description
Pseudouridine synthase, catalyzes only the formation of pseudouridine (Psi)-2819 in mitochondrial 21S rRNA; not essential for viability
Localization:
Intensity:
Fold change:
Significance:
-
C’ GFP library in SD
below threshold16.79 -
N' NOP1pr-GFP in SD
cytosol35.4628 -
N' TEF2pr-mCherry in SD

nucleus36.9306 -
N' NATIVEpr-GFP in SD
below threshold18.9232 -
N' TEF2pr-VC and Cyto-VN in SD

cytosol32.8385 -
C’ GFP library in SD+DTT

cytosol21.121.25No -
C’ GFP library in SD+H2O2

cytosol16.620.98No -
C’ GFP library in Starvation Media

cytosol18.091.07No -
C’ GFP library on the background of Pup2-DaMP

below threshold -
C’ GFP library on the background of CCT mutant

below thresholdN/AN/ANo
